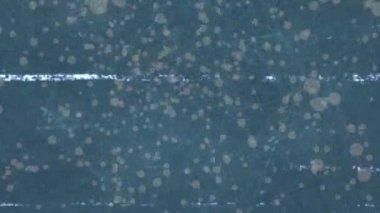
Animation of screen over network of connections. social media and communication concept digitally generated video.

İhlal Bildirim Formu
En Çok Aranan Kelimeler
MaviVintageFilmÇiziklerÜst üste8 mmFilm makarasıRetro görünümToz ParçacıklarıFilm gürültüeski film efektiyaşlı filmFilm dokugrainy filmanalog biçimidistressed filmSinematik Dokudesenli filmKlasik film efektiBenzer İçerikler